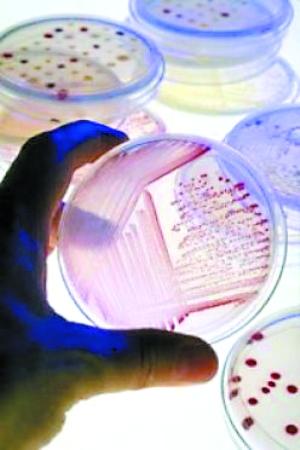

- “人造肉”味道几可乱真 可控制营养成分(图)
科学家已经成功实验室制造出肉类,其味道、营养和组织结构都与真肉无异。
●由单个细胞培养
●可控制营养成分
●方便登月携带
实际上,已有科学家在研究大规模“人造肉”的可行性。他们设想:利用有限的几种成分制成熟悉的食品,将为远征月球和火星的梦想提供重要的生存手段,这比携带大量脱水耐储食品和在太空种植农作物都要方便得多。马萨诸塞州Icosystem公司首席科学家埃里克・波纳博正在美国太空总署(NASA)资助下探索这种可行性。
美国《组织工程》杂志指出:牛或鸡身上的单个肌细胞可以分离出来,培养出成千的新细胞。目前NASA已经用鱼肉组织试验制造出少量鱼肉。马里兰大学的贾森・马西尼博士也提出了两种具有大规模“人造肉”潜力的技术,它们与“真的”肉类相比,味道几可乱真,而且营养和组织结构无异。马西尼说:“你甚至可以控制营养,比如多数肉的Omega 6脂肪酸都较高,人造肉可以用Omega 3代替,这是一种健康的脂肪。”
手机登陆中新网 随时随地知天下【编辑:张艳红】
商讯 >>
${视频图片2010}
本网站所刊载信息,不代表中新社和中新网观点。 刊用本网站稿件,务经书面授权。
未经授权禁止转载、摘编、复制及建立镜像,违者将依法追究法律责任。
Copyright ©1999-2025 chinanews.com. All Rights Reserved













